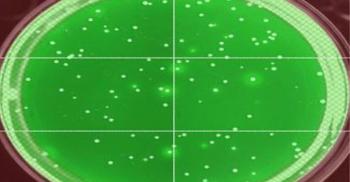

News














The genes that are able to equip bacteria with resistance to clinically used antibiotics have been found in many different natural environments. Nevertheless, a functional overview of the resistance genes found in common human bacterial pathogens has been missing so far. Research from the Novo Nordisk Foundation Center for Biosustainability at the Technical University of Denmark makes it possible to rank the risk of resistance genes and to predict the evolution of existing and future drugs.

After years of investigation, researchers at Johns Hopkins, the University of California, Davis, and the National Institute of Allergy and Infectious Diseases have discovered how the immune system might protect a person from recurrent bacterial skin infections caused by Staphylococcus aureus (staph). The findings, publishing online this week in the Journal of Clinical Investigation, open new doors to someday developing vaccines to prevent staph skin infections, which account for 14 million outpatient visits, nearly 500,000 hospital admissions and $3 billion to $4 billion in inpatient health care costs in the U.S. per year.

The most economical way to kill the bacteria that cause common food-borne illnesses – mostly caused by Salmonella enterica – is heat, but the mechanisms that kill Salmonella at lower temperatures were not fully understood until now, according to a team of researchers.

Recent cases of listeria in food ranging from frozen vegetables to ice cream bars have reinforced the need for better methods of gauging the risk of foodborne pathogen contamination in processing plants. Researchers at the South Dakota State University Department of Dairy and Food Science are responding to the industry’s need for a more comprehensive approach in Listeria risk-assessment.


Influenza activity increased again according to the latest FluView report from the Centers for Disease Control and Prevention (CDC). All U.S. states but Hawaii and Oregon continue to report widespread flu activity and the number of states experiencing high influenza-like illness (ILI) activity increased from 39 states plus New York City and Puerto Rico to 42 states plus New York City and the District of Columbia. At 7.1 percent, influenza-like-illness (ILI) activity is approaching the 7.7 peak of the 2009 pandemic. The overall hospitalization rate is higher than the overall hospitalization rate reported during the same week of the 2014-2015 season; the most severe season in recent years. CDC also is reporting an additional 17 flu-related pediatric deaths, including one of which occurred during the 2015-2016 season, bringing the total number of flu-related pediatric deaths reported this season to 53 so far. Flu activity is likely to remain elevated for several more weeks.

Zika virus may cause significant damage to the fetal brain even when the baby's head size is normal, according to a new animal study led by researchers at the University of Washington School of Medicine in Seattle.

Researchers are paving the way toward a new therapeutic approach for gonorrhea by shedding light on the mechanism behind important proteins on the Neisseria gonorrhoeae bacteria's outer membrane. Future therapies could come in the form of new antibiotics or, even better, a vaccine. The findings are especially important as Neisseria gonorrhoeae is considered a "superbug" because of its resistance to all classes of antibiotics available for treating infections.

How do viruses that cause chronic infections, such as HIV or hepatitis c virus, manage to outsmart their hosts' immune systems? The answer to that question has long eluded scientists, but new research from McGill University has uncovered a molecular mechanism that may be a key piece of the puzzle. The discovery could provide new targets for treating a wide range of diseases.

An international team of researchers has shown that two different compounds-one, an older malaria drug, the other a common laboratory dye with known antimalarial properties-can safely and effectively be added to treatment regimens to block transmission of the most common form of malaria in Africa.


Cellular models of fetal and adult intestinal tissues generated by investigators from the Mucosal Immunology and Biology Research Center (MIBRC) at MassGeneral Hospital for Children (MGHfC) have identified differences in the immune response to natural intestinal bacteria at different developmental ages. The findings, described in a paper published online in Cellular and Molecular Gastroenterology and Hepatology, support the use of this model to investigate conditions including necrotizing enterocolitis (NEC), a dangerous gastrointestinal disease affecting premature infants.
Research on HIV over the past decade has led to many promising ideas for vaccines to prevent infection by the AIDS virus, but very few candidate vaccines have been tested in clinical trials. One reason for this is the technical difficulty of manufacturing vaccines based on the envelope proteins of the virus, according to Phil Berman, who led development of a major component of the only vaccine to have shown any efficacy against HIV in a clinical trial.

Millions of unapproved antibiotics are being sold in India each year, according to a new study published in the British Journal of Clinical Pharmacology. The study also revealed that multinational pharmaceutical companies continue to manufacture dozens of unapproved formulations, despite the global health crisis of rising antimicrobial resistance.


